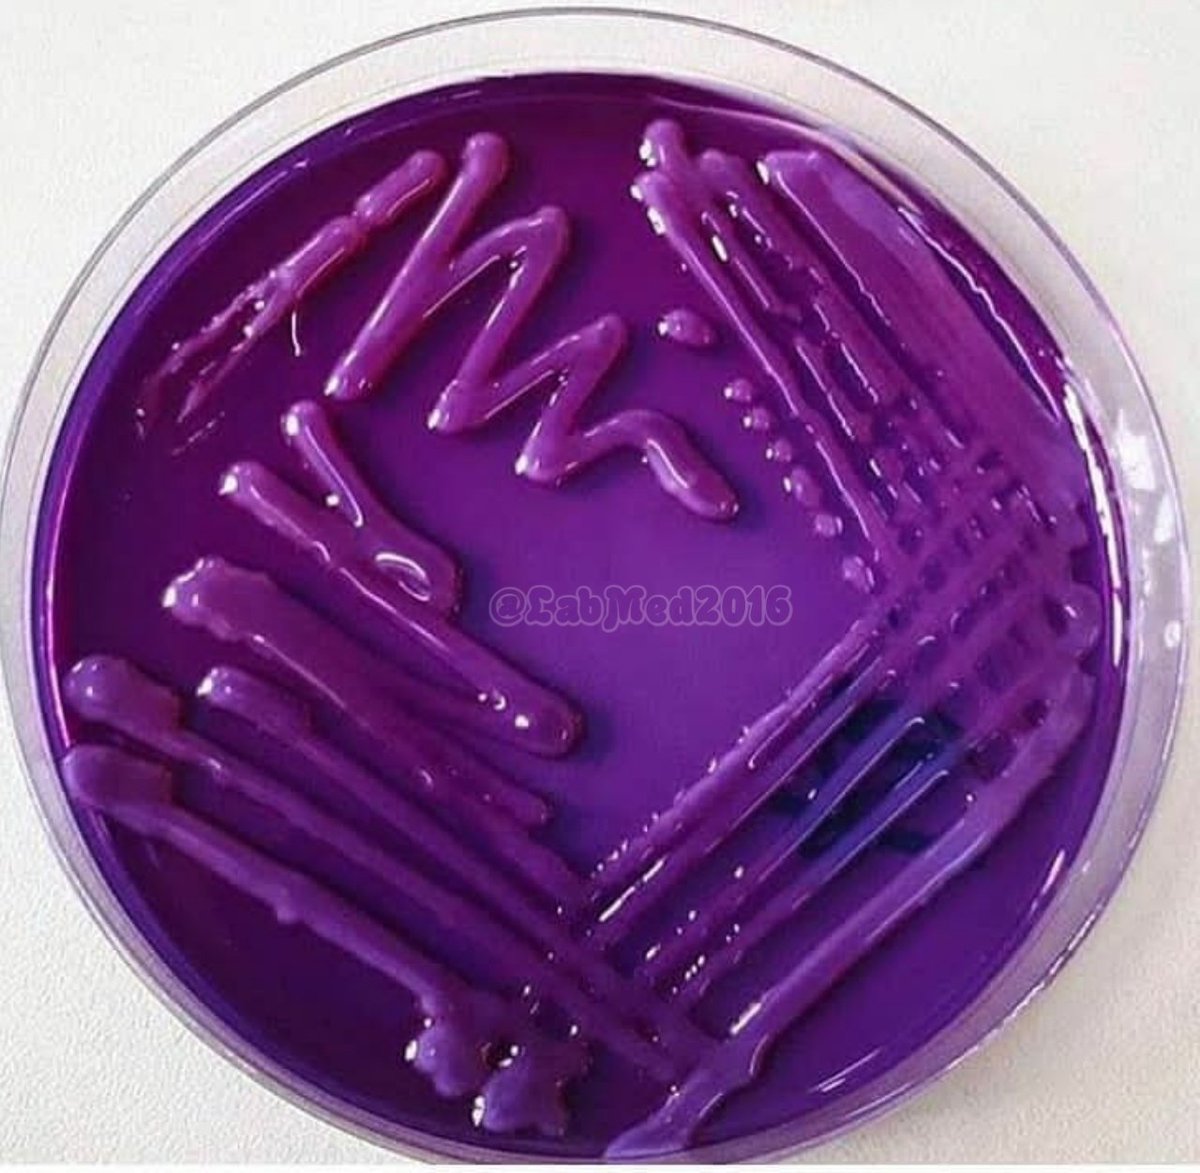
LabMed2016's tweet image. Klebsiella on Drigalski agar

HLPC/FRP/DMLS
@DmlsFrp
medical laboratory .tz candidates of license examination@full registered medical laboratory personnel
You might like
We asked our Patient Champions what they learned from their diagnosis and treatment. "I now know that my purpose in life is to help other cancer patients have a better experience on their journey." - Carly #TheLabSavedMyLife

A middle aged patient who immigrated from India a few months ago presented to the hospital with mid back pain, intermittent fever & weight loss. What is the likely diagnosis? (Image @Radiopaedia, Dr Hani Makky Al Salam) #MedEd



وبسم الله نبدأ مع أول ثريد ✨👏🏻 "Electrolytes"🧪

خمسة تحاليل يجب ان تكون فيها العينه بعيدة عن الضوء المباشر: - • Beta-carotene • Bilirubin • Porphyrins • Vitamin A • Vitamin B6

Klebsiella on Drigalski agar
Sporotrichosis (also known as “rose gardener's disease”) is an infection caused by a fungus called Sporothrix. This fungus lives throughout the world in soil and on plant matter such as sphagnum moss, rose bushes, and hay. #MedTwitter #Medical



A middle aged man who worked as a sandblasting worker for many years p/w chronic cough, fatigue & exertional dyspnea. CXR showed these findings. What is the likely diagnosis? #MedEd #MedTwitter

In a renal transplant recipient, what is your diagnosis? #NephTwitter #renalpath

Attention #MedicalLaboratory majors! CC: Texas State University Clinical Laboratory Science Program @txstscls @txst_CLS lnkd.in/gJx7X_jK
United States Trends
- 1. Sonny Gray 6,097 posts
- 2. Dick Fitts N/A
- 3. #yummymeets N/A
- 4. Red Sox 6,340 posts
- 5. Clarke 5,904 posts
- 6. National Treasure 4,625 posts
- 7. #GMMTV2026 4.17M posts
- 8. Giolito N/A
- 9. Gone in 60 1,594 posts
- 10. Happy Thanksgiving 19.9K posts
- 11. Thankful 49.2K posts
- 12. Raising Arizona N/A
- 13. Academic All-District N/A
- 14. Lord of War 1,169 posts
- 15. Breslow N/A
- 16. Chaim 1,078 posts
- 17. Joe Ryan N/A
- 18. Chuck and Nancy 2,751 posts
- 19. Rush Hour 4 2,631 posts
- 20. Ghost Rider 1,931 posts
You might like
-
 Dakwah Online!! FREE PALESTINE 🇵🇸
Dakwah Online!! FREE PALESTINE 🇵🇸
@DakwahOnline444 -
 Osama
Osama
@Osama_RN -
 Ore Oluwatosin | Virtual Assistant | AI Automation
Ore Oluwatosin | Virtual Assistant | AI Automation
@theuniversalore -
 Mutlaq Alotaibi 💉
Mutlaq Alotaibi 💉
@xs_5u -
 carlifah wizzy J
carlifah wizzy J
@j_carlifah -
 Brad “Bluey”🏴🇦🇺
Brad “Bluey”🏴🇦🇺
@weir813 -
 RN.Ghadeer
RN.Ghadeer
@gm_sh3dow -
 Waqas Yaseen
Waqas Yaseen
@sardarwaqas99 -
 Mram.
Mram.
@MFSu_ -
 Karimzach
Karimzach
@mwambusijr -
 Joanne
Joanne
@JoanneCoog -
 OMAR| عمر
OMAR| عمر
@ii9b25 -
 Haightred
Haightred
@Haightredd -
 m.,,
m.,,
@omfgm4rs_ -
 ThePaulmanac
ThePaulmanac
@thePaulmanac
Something went wrong.
Something went wrong.





















































